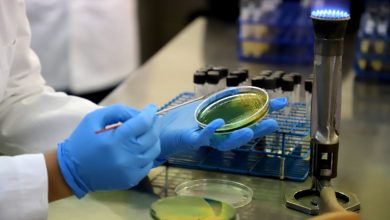

MICHOACÁN
23 de marzo de 2026
Puente Carlos Manzo En La Zona De La Hielera De Uruapan Se Inaugura Este Sábado 28: Bedolla
STAFF/@michangoonga El paso vial Carlos Manzo, ubicado en la zona de La Hielera de Uruapan, será inaugurado el próximo sábado…
HARDNEWS
23 de marzo de 2026
Auto Y Camioneta Protagonizan Choque Sobre La Morelia-Pátzcuaro; Hay Un Lesionado
STAFF/@michangoonga/RED-113 Un auto y una camioneta protagonizaron un choque por alcance sobre la carretera Morelia-Pátzcuaro, en el sentido hacia la…
MORELIA
23 de marzo de 2026
#Morelia ‘Mano A Mano’ JC Barragán Reitera Su Apoyo A Morón Rumbo Al ’27
STAFF/@michangoonga La agrupación ciudadana Mano a Mano refrendó su respaldo al senador Raúl Morón durante el encuentro que sostuvo con…
SOFTNEWS
23 de marzo de 2026
#Morelia Jálate Al “Picnic Del Recuerdo” Este Viernes En Ceconexpo Con Música Romántica Bajo Las Estrellas
STAFF/@michangoonga Este viernes 27 de marzo, la capital michoacana será escenario de una velada musical pensada para las familias y…
HARDNEWS
23 de marzo de 2026
Difunde Poder Judicial La Importancia De La Función Archivística En El Arte De Lo Bueno Y Lo Justo
STAFF/@michangoonga La relevancia de la función archivística radica en la preservación de la memoria histórica, ya que permite a la…
Michoacán
23 de marzo de 2026
«El Pueblo Nos Lo Exige»: Diputada Bugarini Respaldará Plan B De Claudia Sheinbaum
STAFF/@michangoonga La consejera nacional de Morena, Giulianna Bugarini, afirmó que el movimiento de la Cuarta Transformación vive un momento decisivo,…
HARDNEWS
23 de marzo de 2026
#Morelia Para Preservar El Agua Se Ocupa Que Participe La Ciudadanía: Fito Torres
STAFF/@michangoonga En el marco del Día Mundial del Agua, el Organismo Operador de Agua Potable, Alcantarillado y Saneamiento (Ooapas), encabezado…
MICHOACÁN
23 de marzo de 2026
Checate Las Actividades Imperdibles Para Semana Santa En La Zona Lacustre De Michoacán
STAFF/@michangoonga Del 29 de marzo al 19 de abril, la Región Lago se convertirá en el epicentro de la Semana…
NOTA ROJA
23 de marzo de 2026
#Morelia Vuelcan Camioneta Sobre Calzada La Huerta Y La Abandonan
STAFF/@michangoonga/RED-113 Durante la madrugada de este lunes, una camioneta volcada fue abandonada por sus ocupantes sobre la Calzada La Huerta,…
HARDNEWS
22 de marzo de 2026
#Michoacán Vinculan A Jocelyn A Proceso Tras Matar A Su Esposo A Golpes En El 2019
STAFF/ @michangoonga/ RED 113 La Fiscalía General del Estado de Michoacán (FGE) obtuvo vinculación a proceso en contra de Jocelyn…